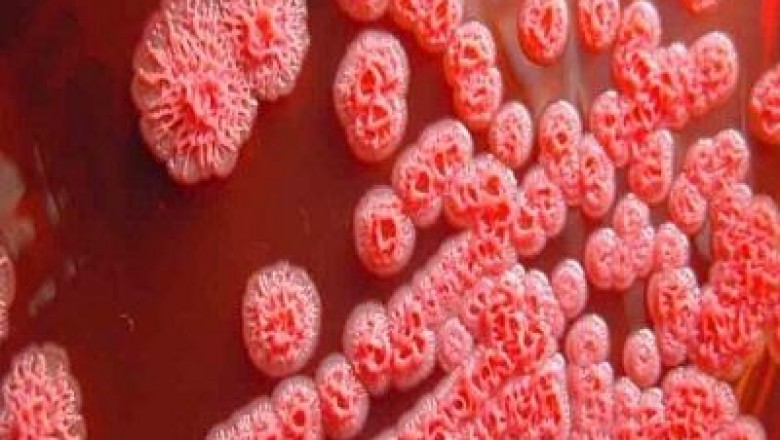

views
Burkholderia infections are caused by Burkholderia cepacia. It is a gram negative bacillus found in aquatic environment. It is a low virulent bacteria and is a frequent colonizer of fluids used in the hospitals such as IV fluid, irrigation solution etc. B. cepacia can cause health problems to some people such as patients suffering from weakened immune system or chronic lung diseases. Burkholderia infection symptom can vary widely in people, ranging from no symptoms to serious respiratory infection.
Increasing prevalence of lung diseases is expected to fuel growth of the Burkholderia infections market. The exact cause for asthma, cystic fibrosis is unknown, though the risk factors can be transferred generation from generation. As per the report of British Lung Foundation, in 2011, an estimated 1.2 million people are living with chronic obstructive pulmonary disease (COPD) and has grown by 27% in the last decade in the U.K. According to the U.S. Cystic Fibrosis Foundation, Europe accounted for the highest number of reported cases of cystic fibrosis in 2012. The growing cases of COPD, asthma and other lung diseases create high risk of burkholderia infection creating an opportunity for manufacturers. Burkholderia infections also cause complications such as soft tissue infections, urinary tract infection and surgical wound infections. It creates an opportunity for the manufacturers to focus on overall treatment. The increasing outbreaks of burkholderia infection has created focus towards the need for proper treatment procedure. Many organization and government policies have included burkholderia infection as one of the severe infections spread from healthcare facilities. Transmission of B. cepacia from contaminated medicines and medical devices. In 2005, CDC notified several states cluster of pneumonia and other infection caused by B. cepacia associated with contaminated mouthwash.